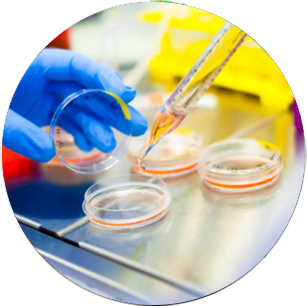

Empowering Global Trade with Excellence and Integrity

We transcend traditional trade boundaries to forge a dynamic connection between cutting-edge products and global marketplaces. Our commitment is not just to facilitate transactions but to create a seamless conduit that integrates the finest innovations with the world's most discerning consumers and businesses.
With an expansive portfolio that stretches across a multitude of sectors, including food products, metals & minerals, chemicals, pharmaceuticals, renewable energy and battery/inverter solutions, we are a nexus of global excellence with strategic foresight.
Our mission is to not only deliver superior quality and reliability,
but to foster enduring partnerships grounded in trust and excellence
• Our food products division meticulously maintains the integrity of quality and freshness from source to table, presenting ingredients that adhere to the most exacting standards.
• Our metals and minerals sector delivers critical materials that energize industries and infrastructures, underscored by an unwavering commitment to reliability and sustainability.
• In the chemical and pharmaceutical portfolio, we offer a sophisticated range of solutions meticulously crafted for diverse applications, guaranteeing both safety and efficacy. Our dedication to health and wellness, presenting medicines and health products that comply with the most stringent global standards.
• As pioneers in the renewable energy sector, we champion the advancement of sustainable technologies, offering products that drive the global transition to cleaner energy sources.


We spearhead the renewable energy sector with pioneering solutions designed for a sustainable future. Our portfolio prominently features high-efficiency solar panels, engineered for exceptional performance and longevity, seamlessly integrating advanced photovoltaic technology with modern aesthetics. Alongside solar energy, we provide an array of cutting-edge renewable technologies, including energy storage systems, all meticulously crafted to optimize energy efficiency and environmental impact. Committed to excellence and innovation, our expert team ensures that every solution adheres to the highest global standards, supporting our mission to foster a greener, more sustainable world.

We deliver sophisticated battery and inverter solutions designed to optimize energy efficiency and reliability. Our high-performance batteries provide robust energy storage for diverse applications, while our advanced inverters ensure precise conversion and management of power. Our street lighting systems integrate smart technology to enhance urban illumination and sustainability. Combining innovation with durability, our solutions are engineered to meet the highest standards of performance and environmental stewardship, making us a leader in modern energy management.

Our Chemicals division excels in delivering a comprehensive array of organic, inorganic and specialized industrial chemicals. We provide premium organic compounds essential for various sectors, robust inorganic materials critical for industrial processes and customized chemicals designed for specialized applications. Each product is meticulously sourced and rigorously tested to ensure unparalleled quality and performance. With our expert guidance and diverse portfolio, we offer tailored chemical solutions that meet the most demanding industry standards and operational requirements.

Enflow General Trading LLC excels in offering a diverse array of high-performance fertilizers tailored for agricultural and industrial applications. We provide a comprehensive selection, including advanced nutrient formulations for optimal crop yield, industrial-grade fertilizers to enhance process efficiency and custom-engineered solutions for specialized industrial needs.Every product is expertly engineered and thoroughly vetted to guarantee exceptional effectiveness and premium quality,delivering targeted solutions that drive productivity and support sustainable practices across various sectors.

We redefine healthcare with a selection of top-tier pharmaceuticals and health gadgets. Our pharmaceutical offerings ensure exceptional quality and efficacy, catering to diverse medical needs with unparalleled reliability. Our sophisticated health gadgets—including advanced health monitors and innovative fitness trackers, integrate seamlessly into your wellness routine, providing insightful data and enhancing your overall health management. Embrace a transformative approach to well-being with our expert solutions.

We thrive in the global electronics arena, presenting an exquisitely curated array of sophisticated consumer electronics, state-of-the-art home appliances, high-performance industrial technology and comprehensive networking solutions. Our expertise grants access to the latest innovations, from cutting-edge smartphones and intelligent home devices to advanced industrial automation systems and precision measurement tools. Committed to unparalleled service and exceptional quality.

Enflow General Trading LLC present a distinguished assortment of the newest smartphones, thoughtfully curated to showcase the pinnacle of mobile innovation. Our selection includes top-tier devices equipped with state-of-the-art processors, exquisite displays and advanced camera systems, guaranteeing an unmatched level of connectivity and technological advancement. Whether you're in pursuit of high-end models with revolutionary features or more economical options with dependable performance, our collection is crafted to enhance your mobile experience and ensure you remain at the forefront of technology.

We elevate the realm of fashion by offering a stunning collection of garments that seamlessly blend timeless elegance with modern flair. Our carefully curated array showcases apparel that epitomizes both sophistication and style, crafted to the highest standards of quality. Dive into our selection where classic silhouettes effortlessly merge with contemporary trends, from exquisitely tailored suits and elegant dresses to stylishly casual wear. Each piece is crafted from premium materials with meticulous attention to detail, ensuring a perfect fit and enduring appeal.

Discover a distinguished assortment of leather goods that merge timeless charm with exceptional resilience. Our exclusive collection showcases a range of finely crafted leather accessories, seamlessly integrating classic sophistication with contemporary needs. Dive into our selection, featuring everything from beautifully tailored leather jackets and chic handbags to opulent wallets and elegant belts. Each piece is made from premium-grade leather, offering a plush feel and enduring durability, with every detail reflecting superior artisanal skill. Whether you're searching for a standout accessory that complements your unique style or versatile essentials that add a touch of luxury to daily wear, our leather offerings are designed to meet the highest standards of refinement and longevity.

We redefine the possibilities of plastic products through our sophisticated and diverse selection, to meet the highest standards of quality and innovation. Explore our extensive portfolio, which includes high-impact industrial components. Our selection also features advanced automotive parts, including custom fittings and protective housings, designed for both reliability and efficiency. We offer stylish and functional household items like kitchen utensils, sleek storage solutions, versatile packaging materials that combine durability with aesthetic appeal. Our offerings extend to consumer goods like trendy phone cases and customizable promotional items, providing innovative solutions that cater to diverse needs.

With source elite selection of metals and minerals with diverse portfolio features high-grade metals like stainless and carbon steel, renowned for their strength and durability; versatile metals including aluminum and copper, each offering unique properties for a range of applications. Our industrial minerals and rare earth elements provide end solutions for advanced manufacturing and technology. Each material is sourced with precision and designed to meet the highest standards, ensuring that we deliver excellence that drives innovation and success in a dynamic marketplace.